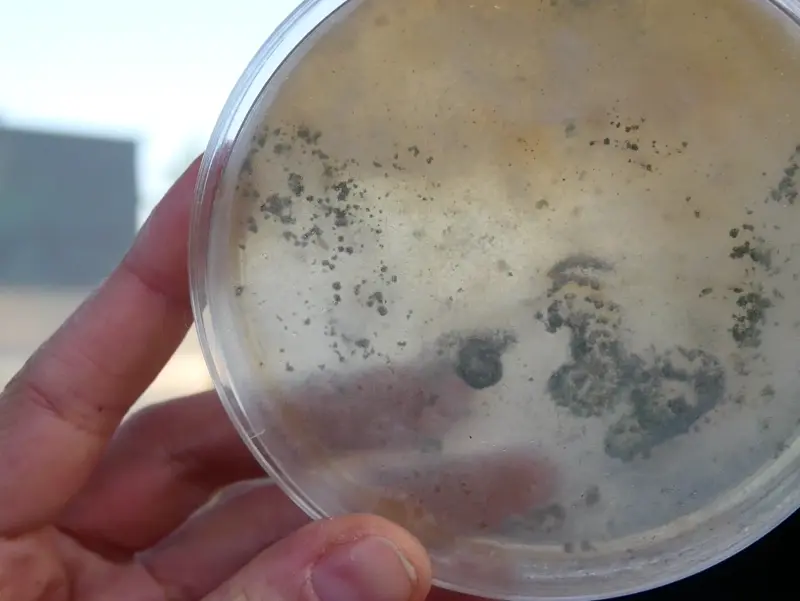
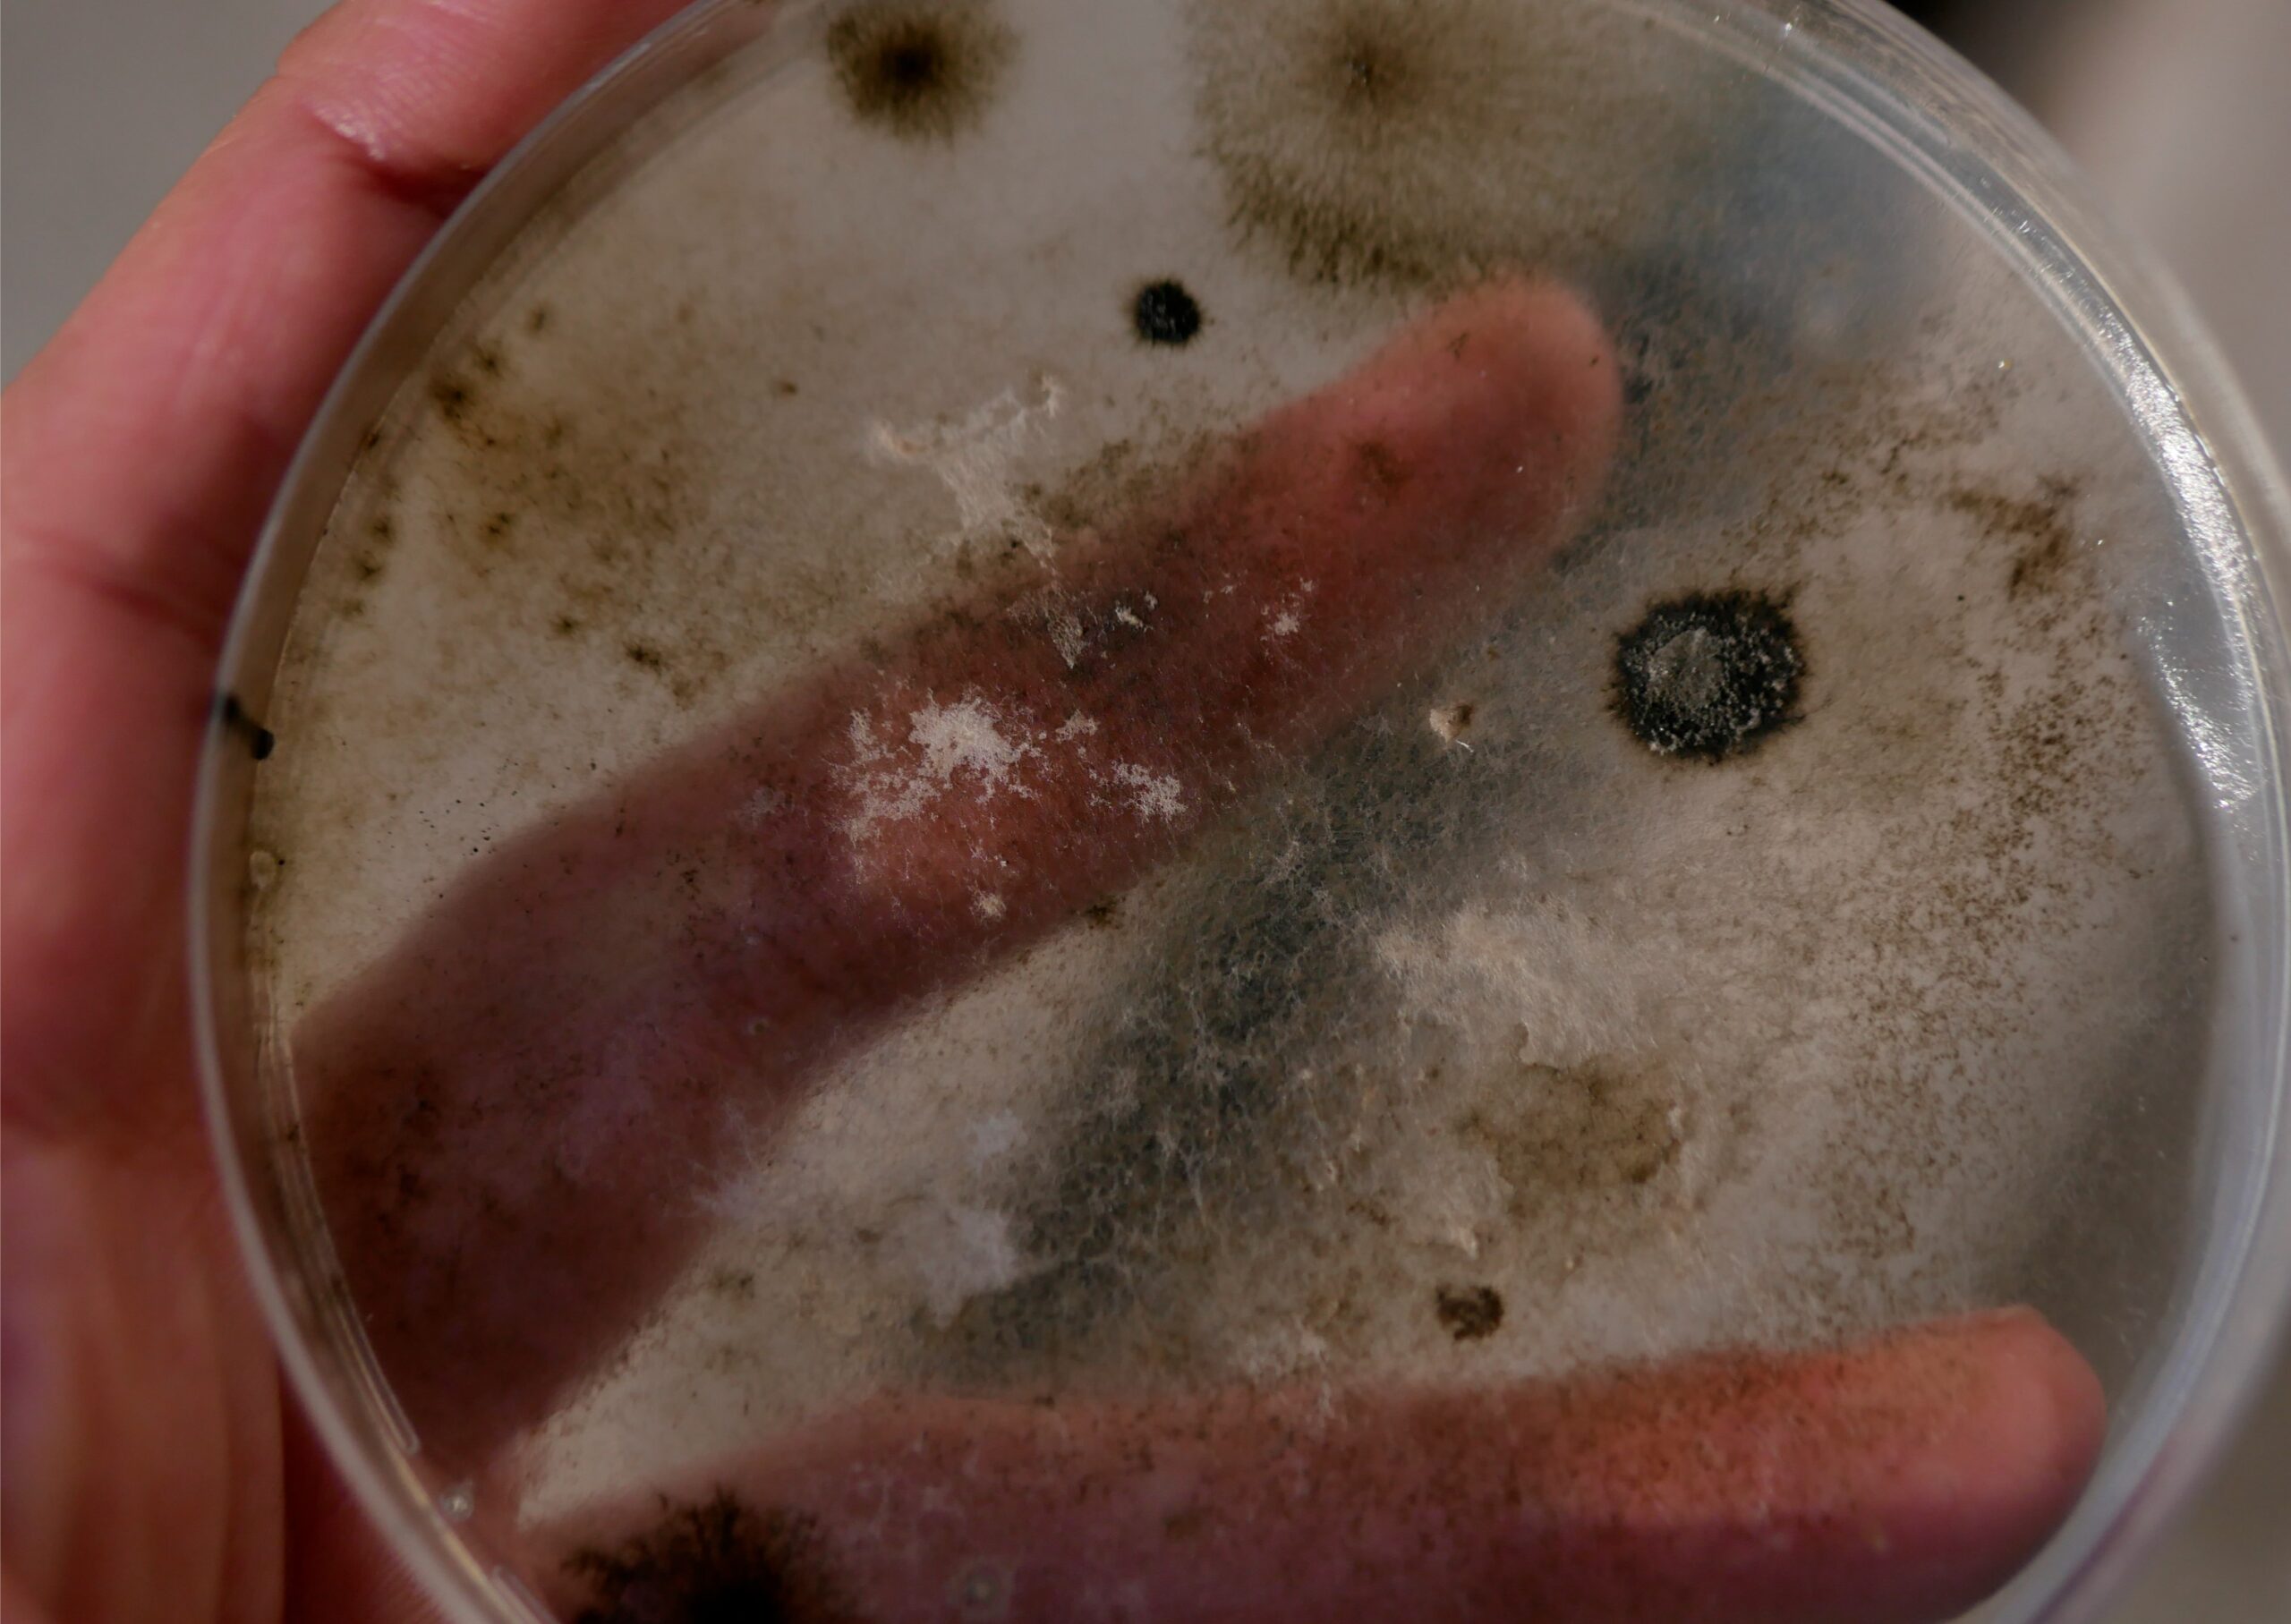

ESPORAS DERIVAS ARTÍSTICAS VINCULANTES
Esporas: Derivas Artísticas Vinculantes - 2022 a la fecha
Coautoría junto a Katya Noriega.
Plataforma de creación/investigación interdisciplinaria que parte de preguntas como: ¿Cuál es la potencia creadora y transformadora del arte en el presente? ¿Cuáles son los procedimientos y estrategias de producción que habilitan otras posibilidades de hacer, pensar y de coexistir? ¿Cómo crear alianzas estético-afectivas con otras especies y con la materia entendida como existencia animada?
Inspirado en metáforas biológicas y existencias simbióticas de hongos, bacterias y plantas, el proyecto se propone analizar y explorar metodologías de creación que atienden a procesos de intercambio, disipación y proliferación de modos de existencia disidentes como materiales de producción de saberes, ubicándose en un espacio liminal entre reivindicaciones políticas sobre cuidados ecológicos y sociales, propuestas generadas desde el medio artístico y saberes ecológicos. Nombramos estas metodologías, como “Metodologías fúngicas” (2024), ya que sus principales modos de composición y características se pueden vincular a procesos propios de los hongos. El proyecto ha explorado distintos formatos artísticos entre los que destacan la performance, el video y laboratorios/talleres.
Fondo de las Artes Escénicas, modalidad investigación teórica, 2022. Folio 630406.
Proyecto nominado para Premios MUTA 2024, categoría investigación.
www.proyectoesporas.art - IG @proyectoesporas
Ensayo audiovisual “Esporas, derivas artísticas vinculantes”
El ensayo audiovisual “Esporas derivas vinculantes” forma parte del proyecto que lleva el mismo nombre y aborda parte de las preguntas, análisis y propuestas especulativas generadas en este. Se alimenta de archivos de val flores, Lucia Egaña y Laboratorio de Artistas Sostenibles que acompañaron este proceso, así como de experimentaciones escénicas, residencias y compartires que ayudaron a agitar y fermentar nuestras intuiciones iniciales.

Dispositivo escénico “Ensambles ineludibles”
Ejercicio escénico que indaga en las nociones de interdependencia y cuerpo plural a partir del cultivo de microbiota y moho. También es una invitación a (des)componer la mirada, ceder y dilatar nuestra pupila para aproximarnos a las opacidades de cuerpos que importan poco, que son invisibles o que “valen hongo”.
Distintos formatos de esta performance han sido presentados en Residencia Artes Vivas, Centro NAVE (Santiago, Chile, 2023), Encuentro FAD en Centro Cultural España (Santiago, Chile, 2023), Residencia NdP (Noche de Performance) CEINA (Santiago, Chile, 2023) y 2° Festival del Hongo (Villa Alemana, Chile, 2024)
Laboratorios y experiencias educativas
“Respirar y masticar laboratorio de prácticas especulativas y elaboración de papel”
FAD (Santiago, Chile. 2024)
En este laboratorio se proponen exploraciones vinculadas al movimiento y la escritura, para luego explorar la descomposición desde la masticación de nuestras producciones textuales, el remojo y fermentación de estas, con el fin de componer un nuevo sustrato colectivo, desde el reciclaje y elaboración de papel.
Así, en este laboratorio creativo, compartimos una experiencia somática de vinculación entre cuerpos por medio de la respiración, el tacto y el masticar, donde se habilite el tránsito, la difuminación como espacio de encuentro. Desde preguntas como ¿Qué secreciones envuelven nuestras cercanías? ¿Cuál es el lugar de nuestro cuerpo en nuestras producciones artísticas y cotidianas? ¿Cómo se puede poner de/con otras formas el cuerpo? queremos elaborar gestos especulativos que re-mapeen nuestra comprensión anatómica pensando en otras proximidades y cultivando otras (des)composiciones con la materia.






“Borrador para un imaginario de gestos linguales”
Junto a Lucía Egaña y María Landeta, en Casa Taller Teatro Sur. (Santiago, Chile. 2023)
Durante este taller se proponen algunos procedimientos de degustación a través de prácticas físicas, escriturales y de la creación de un archivo gestual y verbal, que pasan por el ejercicio lingual. Así, se buscan formas no patriarcales de mirar, al margen del oculocentrismo, forma de visión que busca la amplificación del sentido probatorio del ojo. En cambio, se exploran formas de mirar con otras partes del cuerpo, desde los gestos linguales, mojados, a veces obscenos o palabreados, en la práctica del lenguajeo.
Proponemos considerar los fluidos corporales como líquidos de contra-miradas que se desplazan de la nitidez del conocimiento oficial. Permitiéndonos indagar en distintos grados de sombra, en lo velado, lo que muestra un contorno borroso, como sabores amargos, ácidos, que tensionan el binarismo dulce/salado. El lagrimal y las papilas gustativas como glándulas de la mirada. ¿Cómo se revelan los saberes de esos gestos? ¿Es posible describirlos en las penumbras de lo táctil? ¿Qué saberes acerca de la mirada conoce la lengua lesbiana? ¿Qué sabores olvidados de la lengua se esconden en las prácticas lesbianas?



Laboratorio “Ensambles ineludibles. Proyecto Esporas: derivas artísticas vinculantes”
Residencia Centro NAVE (Santiago, Chile. 2023)
Laboratorio de experimentación creativa que busca explorar una metodología de afectación aumentada como modo de vinculación simbiótica entre microbiota, cuerpos, textos e imágenes.
Considerando los ensambles ineludibles entre materias y especies que nos conforman y el reconocimiento de la interdependencia que cuestiona los límites y nociones de individualidad, buscamos comprender las posibles conexiones entre los diferentes microorganismos que conforman nuestro cuerpo a partir del concepto Holobionte, el movimiento y la figuración especulativa desde las prácticas somáticas.



Libro “Esporas: derivas artísticas vinculantes”
El libro digital del proyecto contiene la recopilación de los análisis y propuestas especulativas generadas a lo largo de este, alimentadas por los archivos, geografías, formas y cotidianos de val flores, Lucia Egaña y el colectivo Laboratorio de Artistas Sostenibles, que componen el corpus de este texto y acompañaron su escritura.
Creación e investigación: Andrea Jert Bustos y Katya Noriega Arancibia
Asesor teórico: Jorge Diaz
Diseño gráfico libro digital: Belén Segú @belenabels
Artistas colaboradoras:
val flores
Lucía Egaña Rojas
L.A.S (Laboratorio de Artistas Sostenibles)